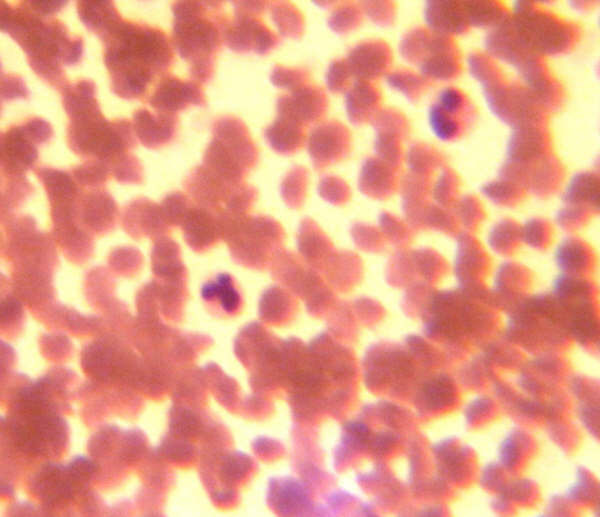
practicas

Departamento de Ciencias Naturales
TINCIÓN DE CÉLULAS SANGUÍNEAS
- Curso: 4º ESO
Se procede de la siguiente manera:
1) Se pincha un dedo con una lanceta estéril a los alumnos y se deja caer una o dos gotas de sangre en el portaobjetos.
2) Con otra portaobjetos limpio se extienden las gotas de sangre. Se le añade alcohol para fijar la práctica y se le añade Violeta de Genciana durante cinco minutos. Se lava y se vuelve a dejar secar.
3) Se le añade un cubreobjetos y observaremos los glóbulos blancos.
Algunas observaciones realizadas por nuestros alumnos han sido las siguientes:
- Curso: 4º ESO
Se procede de la siguiente manera:
1) Se pincha un dedo con una lanceta estéril a los alumnos y se deja caer una o dos gotas de sangre en el portaobjetos.
2) Con otra portaobjetos limpio se extienden las gotas de sangre. Se le añade alcohol para fijar la práctica y se le añade Violeta de Genciana durante cinco minutos. Se lava y se vuelve a dejar secar.
3) Se le añade un cubreobjetos y observaremos los glóbulos blancos.
Algunas observaciones realizadas por nuestros alumnos han sido las siguientes: